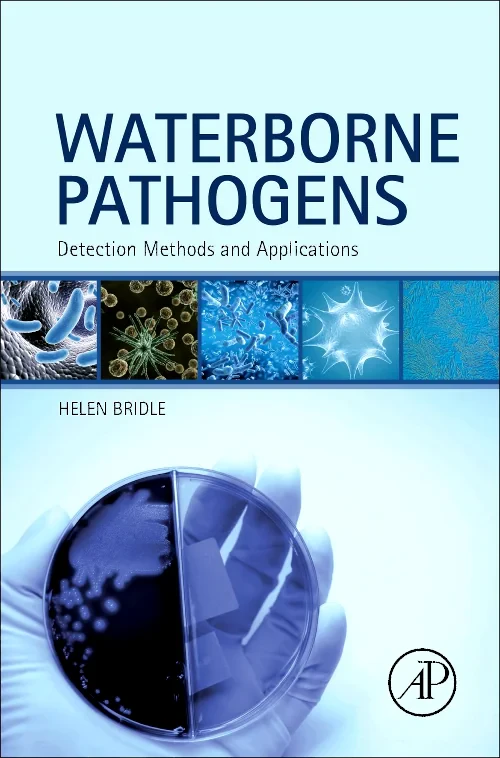
Waterborne Pathogens

- Home
-
Products
- Activitati educative
- Afaceri și economie
- Agende si calendare
- Albume de arta
- Alte Categorii
- Antichități și Obiecte de Colecție
- Arhitectură
- Arhitectura si Design
- Artă
- Arte lingvistică și disciplinele conexe
- Arte și spectacol
- Beletristica
- Biblioteconomie și Știința Informării
- Biologie moleculară, celulară și a dezvoltării
- BlackFriday
- Business si dezvoltare profesionala
- Calculatoare
- Carti copii
- Carti Prior
- Carti rare
- Chimie și Inginerie Chimică MRW
- Crime real
- Dezvoltare personală
- Dezvoltare personala si psihologie
- Drept
- Educație
- Educație RO
- Educaţie şi copii
- Filosofie
- Fotografie
- Geologie
- Hobby si lifestyle
- Istorie
- IT & tehnologie
- Jocuri și Activități
- Managementul Afacerilor
- Manuale de Matematică
- Matematică
- Medicină
- Medicina si famacie
- Medicina si farmacie
- Medicină Veterinară
- Metode în enzimologie
- Muzică
- Natură
- Non-ficțiune pentru copii
- Nursing
- oldBF
- Partituri
- Profesii din domeniul sănătății
- Psihologie
- Referință
- Reviste
- Sănătate
- Soluții Clinice DE
- Sport și recreere
- Știință
- Stiinte
- Științe politice
- Științe sociale
- Stinta si tehnica
- Stomatologie
- Tehnologie și Inginerie
- Transport
Activitati educative
No subcategories See all
- Industrii
- Managementul producției și al operațiunilor
- Management
- Contabilitate
- Economie
- Controlul Calității
- Management Industrial
- Bănci și servicii bancare
- Managementul facilităților
- Luarea deciziilor și rezolvarea problemelor
- Managementul Informației
- Marketing
- Antreprenoriat
- Dezvoltare
- Resurse Umane & Managementul Personalului
- Dezvoltare organizațională
- Investiții și titluri de valoare
- Planificare strategică
- Matematică aplicată în afaceri
- Comportamentul consumatorului
- Econometrie
- Finanțe corporative
- Finanțe personale
- Cercetare Operațională
- Comunicare în afaceri
- Afaceri ecologice
- Finanțe publice
- Cariere
- Pregătire
- Istorie economică
Biologie moleculară, celulară și a dezvoltării
No subcategories See all
BlackFriday
No subcategories See all
- Administrare Sistem
- Arhitectură Calculatoare
- Dezvoltare software și inginerie
- Administrare și gestionare baze de date
- Teoria Informației
- Programare
- Interacțiunea Om-Calculator
- Software matematic și statistic
- Sisteme de operare
- Sisteme informatice de management
- Software educațional
- Sisteme Distribuite
- Aspecte sociale
- Realitate virtuală și augmentată
- Managementul documentelor
Carti copii
No subcategories See all
Carti rare
No subcategories See all
Crime real
No subcategories See all
Dezvoltare personala si psihologie
No subcategories See all
- Administrație
- Psihologie Educațională
- Filozofie, Teorie și Aspecte sociale
- Finanțe
- Școli
- Stiluri de învățare
- Educație pentru adulți și educație continuă
- Didactic
- Testare și Măsurare
- Evaluare și Testare
- Scopuri și Obiective
- Manuale școlare
- Leadership
- Educație specială
- Învățământ la Distanță, Deschis & Online
Educație RO
No subcategories See all
- Instrumente & Consumabile
- Evaluarea riscurilor pentru sănătate
- Sănătate Mintală
- Medicină Tropicală
- Medicină Legală
- Medicină și Tehnologie Reproductivă
- Dietoterapie
- Biostatistică
- Administrarea spitalelor și îngrijire
- Chimioterapie
- Chirurgie vasculară
- Medici și Pacienți
- Radiologie - Neurologică
- Medicină de laborator
- Controlul infecțiilor
Metode în enzimologie
No subcategories See all
Non-ficțiune pentru copii
No subcategories See all
- Pregătire pentru teste și evaluări
- Fiziopatologie
- Farmacologie
- Urgențe
- Referință
- Generale
- Nutriție
- Referințe despre medicamente
- Gerontologie
- Psihiatrie și Sănătate Mintală
- Îngrijire la domiciliu și comunitară
- Medicină critică și terapie intensivă
- Management & Leadership Management și Leadership
- Oncologie și cancer
- Asistent medical & Pacient
- Pediatrie și Neonatologie
- Fundamente & Abilități
- Evaluare și diagnostic
- Aspecte sociale, etice & legale
- Asistent medical acreditat & Asistent medical licențiat
- Cercetare și teorie
- Medicină și chirurgie
- Anatomie și Fiziologie
- Asistent medical
- Medical Surgical - Manuale
- Boli infecțioase
- Educ/Training/Dezvoltare personală
- Planuri de îngrijire
- Anestezie
- Med-Surg - Referințe avansate
- Psihoterapie
- Psihologie clinică
- Dezvoltare personală
- Psihologie cognitivă & Cogniție
- Psihologie socială
- Psihologie experimentală
- Psihologie aplicată
- Personalitate
- Neuropsihologie
- Psihologie industrială și organizațională
- Psihologie fiziologică
- Psihologie judiciară
- Neuroștiințe cognitive & Neuropsihologie cognitivă
- Psihopatologie
- Curente literare
Soluții Clinice DE
No subcategories See all
- Optică
- Cartografie
- Radio
- Petrol
- Minerit
- Industrii Tehnice & Prelucrătoare și Meserii
- Senzori
- Comunicații mobile și wireless
- Pescuit & Acvacultură
- Combatere dăunători
- Fibră Optică
- Teledetecție și Sisteme Informatice Geografice
- Desen Tehnic & Desen Mecanic
- Supraconductori și Supraconductibilitate
- Lasere și Optică
- Faq
- Contact